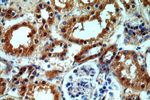
HECTD1 Antibody in Immunohistochemistry (Paraffin) (IHC (P))

Search
Proteintech
HECTD1 Polyclonal Antibody
{{$productOrderCtrl.translations['antibody.pdp.commerceCard.promotion.promotions']}}
{{$productOrderCtrl.translations['antibody.pdp.commerceCard.promotion.viewpromo']}}
{{$productOrderCtrl.translations['antibody.pdp.commerceCard.promotion.promocode']}}: {{promo.promoCode}} {{promo.promoTitle}} {{promo.promoDescription}}. {{$productOrderCtrl.translations['antibody.pdp.commerceCard.promotion.learnmore']}}
产品信息
20605-1-AP
种属反应
已发表种属
宿主/亚型
分类
类型
抗原
偶联物
形式
浓度
规格
纯化类型
保存液
内含物
保存条件
运输条件
产品详细信息
Immunogen sequence: PGFLRFVRV LCGMSSDERK AFLQFTTGCS TLPPGGLANL HPRLTVVRKV DATDASYPSV NTCVHYLKLP EYSSEEIMRE RLLAATMEKG FHLN (29-121 aa encoded by BC006237)
靶标信息
Probable E3 ubiquitin-protein ligase which accepts ubiquitin from an E2 ubiquitin-conjugating enzyme in the form of a thioester and then directly transfers the ubiquitin to targeted substrates. May be required for development of the head mesenchyme and neural tube closure.
仅用于科研。不用于诊断过程。未经明确授权不得转售。
生物信息学
蛋白别名: E3 ligase for inhibin receptor; E3 ubiquitin-protein ligase HECTD1; EULIR; HECT domain containing E3 ubiquitin protein ligase 1; HECT domain-containing protein 1; HECT-type E3 ubiquitin transferase HECTD1; protein open mind; unnamed protein product
基因别名: A630086P08Rik; AI844876; b2b327Clo; EULIR; HECTD1; KIAA1131; opm
UniProt ID: (Human) Q9ULT8
Entrez Gene ID: (Human) 25831, (Mouse) 207304